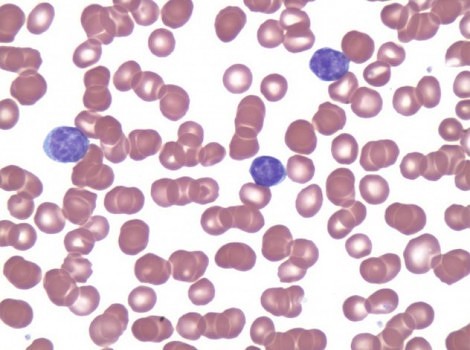

Category: Da li znate


Naučnici žele oživeti 24 izumrle životinje

Modna kuća napravila odelo koje blokira elektromagnetne talase

Petogodišnjakinja otkrila novu vrstu dinosaurusa
Rak zaustavljen pomoću modifikovanih ćelija pacijenata

Pčele ne posećuju dva puta isti cvet

Američki studenti razvijaju helikopter na ljudski pogon

10 glavnih saveta za ishranu astronauta u svemiru

Student izumeo gel koji u par sekundi zaustavlja krvarenje
